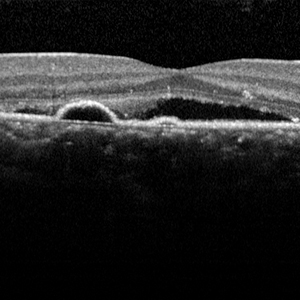

Age-related macular degeneration (AMD)
AMD is one of the commonest causes of visual loss in those older than 50 years of age. Early in the disorder, vision becomes distorted or blurred but in advanced cases, central vision can be lost completely. The decline in central vision makes reading, recognising faces, watching television and driving more difficult. Early signs of AMD include deposits at the macula called drusen. At late stages, AMD can be classified as either dry or wet. In dry AMD, there is progressive loss of cells and thinning at the macula. In wet AMD, bleeding or leakage of fluid in the macula causes rapid loss of vision unless urgent treatment is initiated.
Read More Here.
Diabetic eye disease
Diabetes is a chronic health condition that affects several organs in the body including the eye. Besides accelerating the formation of cataract and increasing the risk of eyelid infections, the retina is the main tissue affected by diabetes. Two different problems, retinopathy and maculopathy, affect the retina of patients with diabetes. Diabetic retinopathy affects the whole of the retina. In the early stages, small haemorrhages and microaneurysms appear in the retina. Later in the disease, larger haemorrhages and multiple areas of blocked blood supply develop which commence development of abnormal new vessels within the retina. Untreated, this can lead to big bleeds within the jelly of the eye (vitreous), retinal detachment and eventual loss of sight. Simultaneously, leakage and accumulation of fluid within the most sensitive part of the retina, called the macula can transpire. This condition is called diabetic maculopathy and it also results in the blurring of vision. The treatment of these conditions includes injections in the eye or retinal laser.
Read More Here.